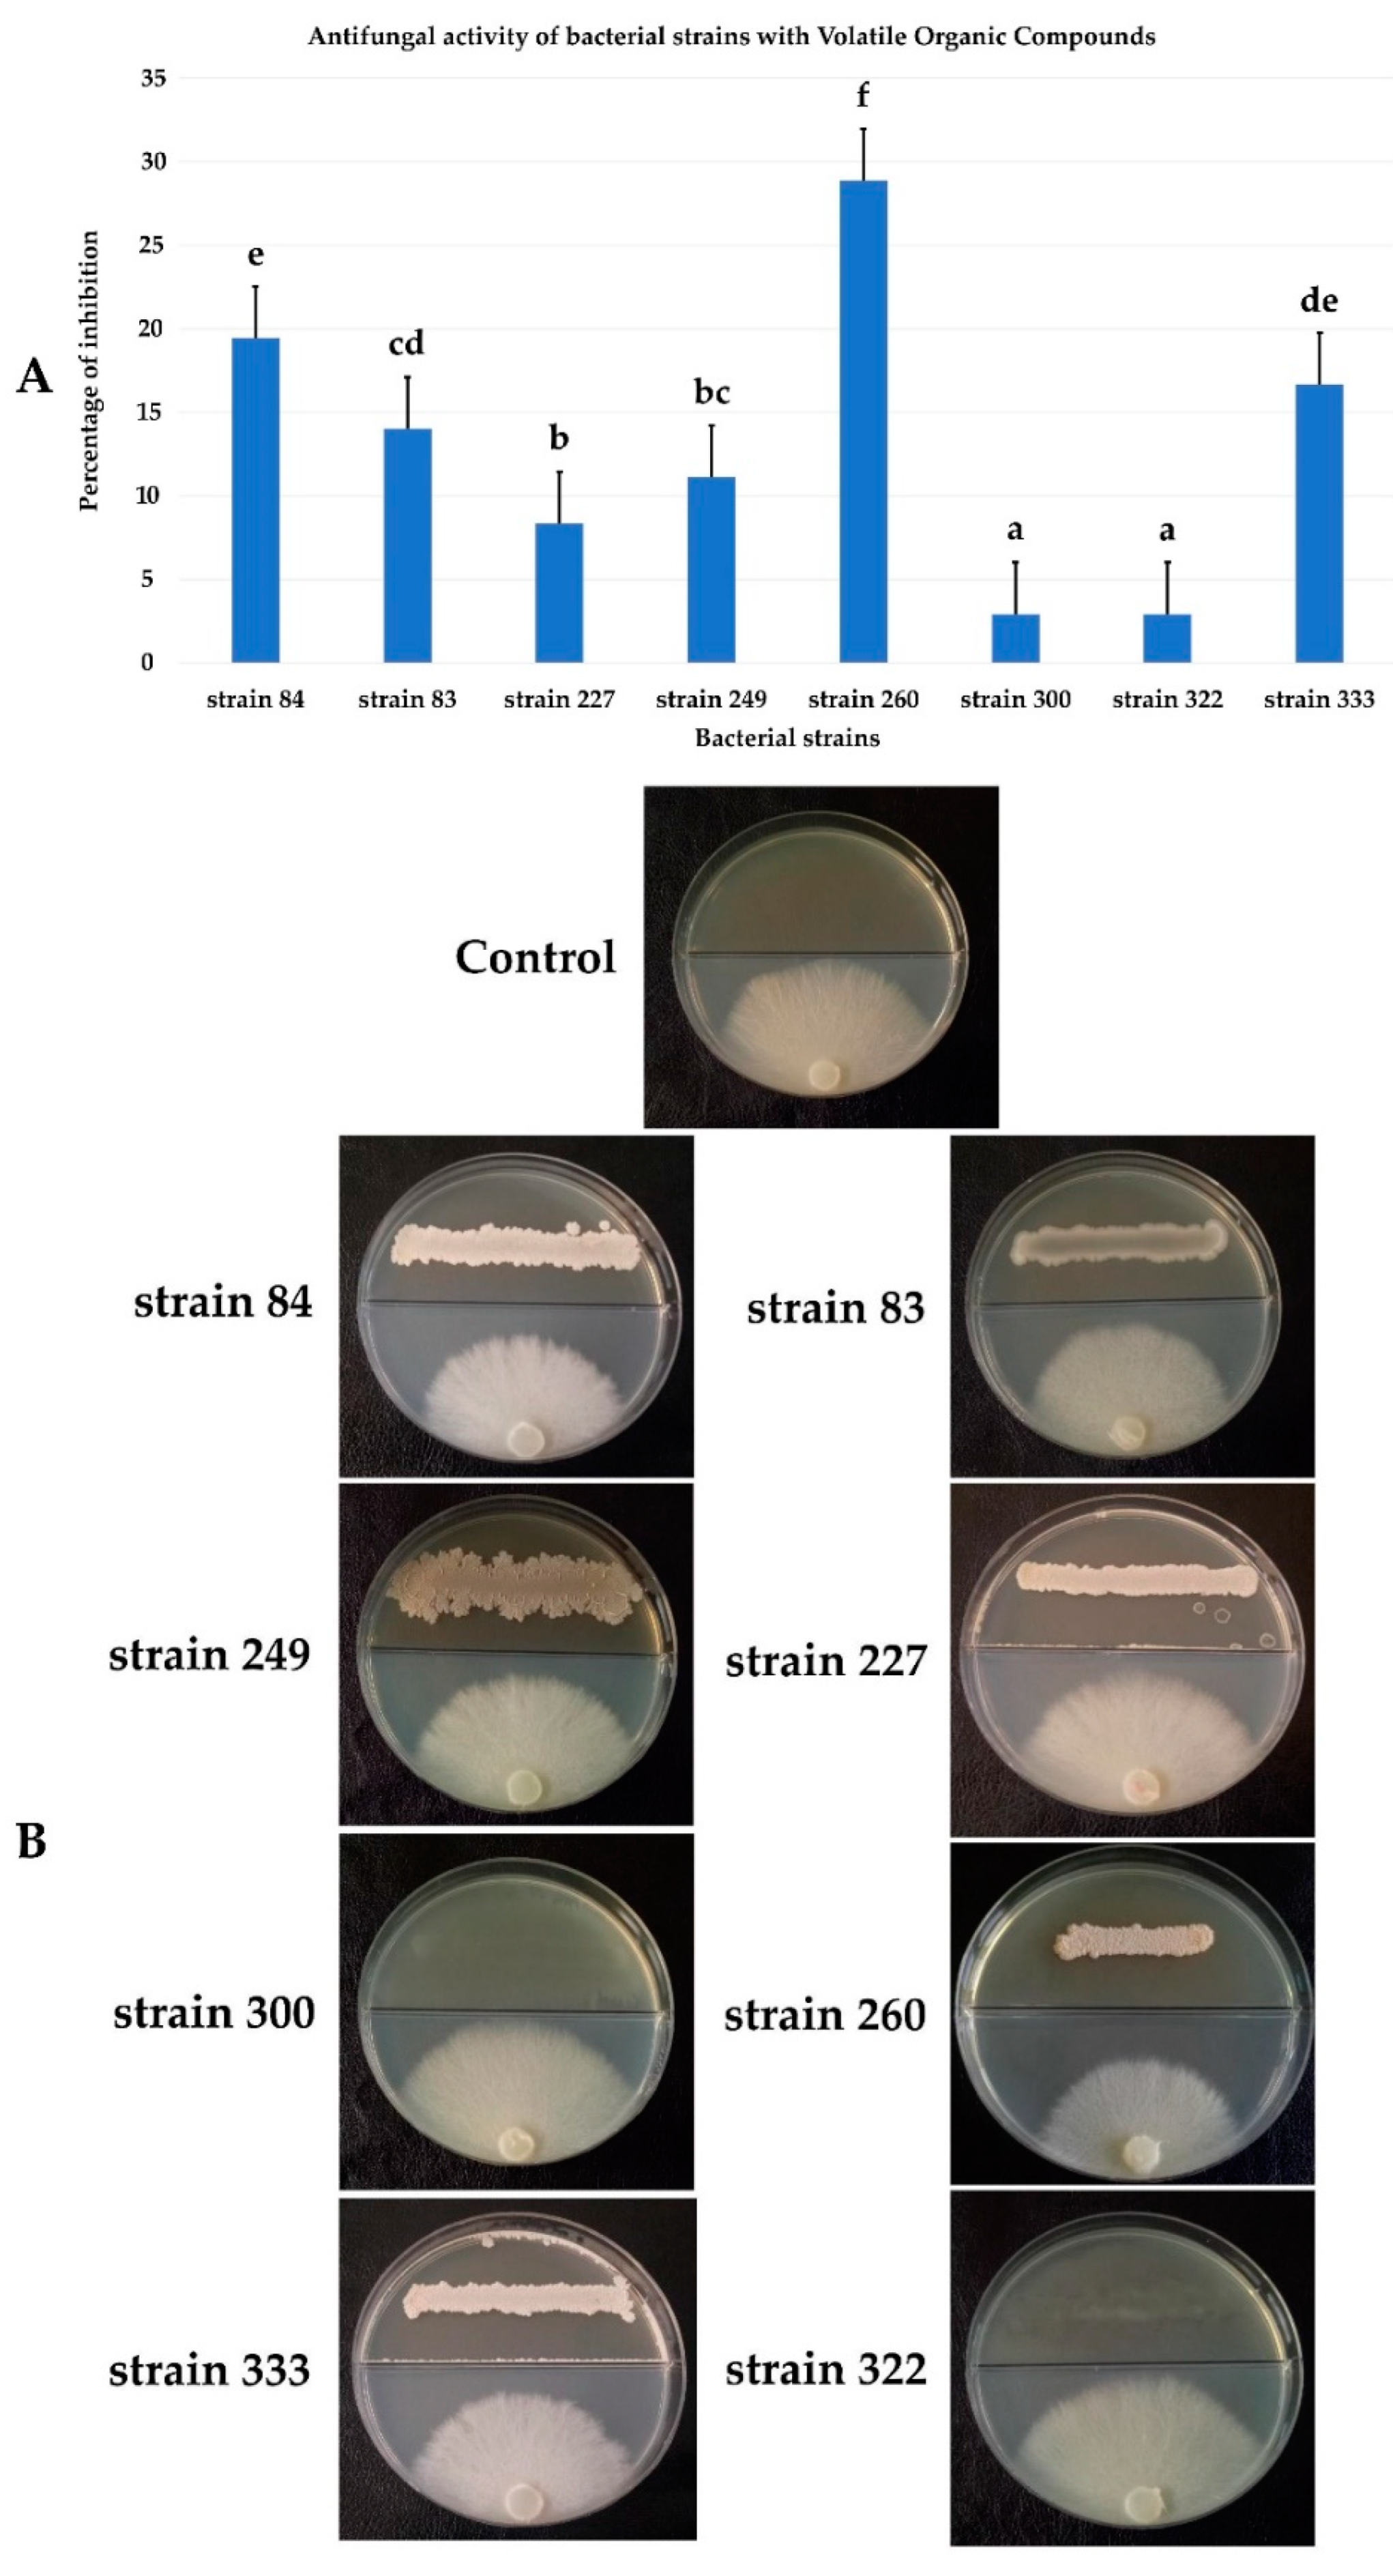
Agronomy 12 02403 g008

Critical Evaluation of Biocontrol Ability of Bayoud Infected Date Palm Phyllospheric Bacillus spp. Suggests That In Vitro Selection Does Not Guarantee Success in Planta
Abstract
:1. Introduction
2. Materials and Methods
2.1. Description and Location of Sampling Sites
2.2. Isolation and Screening of Antagonistic Bacterial Strains
2.2.1. Bacteria Isolation
2.2.2. Fungal Isolates
2.2.3. Screening for In Vitro Antagonism
2.3. Antifungal Potential of Selected Isolates
2.4. Molecular Characterization of Selected Bacterial Strains
2.5. Antagonistic Effect of Bacterial Co-Culture
2.6. Antagonistic Effect of Cell-Free Supernatant
2.7. Antifungal Activity by Volatile Organic Compounds (VOCs)
2.8. In Vivo Biocontrol Assay for the Reduction in Date Palm Root Disease Using Selected Bacteria
2.9. Effect of Salt, pH, PEG, and Temperature on the Growth of Bacterial Strains
2.10. Determination of Resistance to Heavy Metals
2.11. PGP Potentialities of Bacterial Isolates
2.12. Screening for Bacterial Hydrolytic Enzymes
2.13. Statistical Analyses
3. Results
3.1. Enumeration, Isolation, and Selection of Antagonistic Bacteria
3.2. Biocontrol Ability of Bacterial Isolates towards FOA and Other Phytopathogenic Fungi
3.3. Molecular Identification of Bacterial Strains and Their Phylogenetic Positions
3.4. Effect of Bacterial Co-Culture on FOA Growth
3.5. Effect of Cell-Free Culture Supernatant on FOA Growth
3.6. Antifungal Activity by Volatile Organic Compounds (VOCs)
3.7. In Vivo Biocontrol Test on Germinated Date Palm Seeds
3.8. Effect of Salt, pH, PEG, and Temperature on the Bacterial Growth of Strains
3.9. Determination of Resistance to Heavy Metals
3.10. PGP Potentialities of Selected Strains
3.11. Production of Hydrolytic Enzymes
4. Discussion
5. Conclusions
Supplementary Materials
Author Contributions
Funding
Institutional Review Board Statement
Informed Consent Statement
Conflicts of Interest
References
- Djerbi, M. Précis de Phéniciculture. ED; FAO: Rome, Italy, 1994; p. 192. [Google Scholar]
- Hassan, M.M.; Allam, M.A.; Shams El-Din, I.M.; Malhat, M.H.; Taha, R.A. High-frequency direct somatic embryogenesis and plantlet regeneration from date palm immature inflorescences using picloram. J. Genet. Eng. Biotechnol. 2021, 19, 1–11. [Google Scholar] [CrossRef]
- De la Perrière, R.B.; Amir, H.; Bounaga, N. Prospects for integrated control of ‘bayoud’ (Fusarium wilt of the date palm) in Algerian plantations. Crop Protect. 1995, 14, 227–235. [Google Scholar] [CrossRef]
- Sidky, R. Optimized direct organogenesis from shoot tip explants of date palm. In Date Palm Biotechnology Protocols; Humana Press: New York, NY, USA, 2017; Volume 1, pp. 37–45. [Google Scholar]
- FAOSTAT. Available online: http://www.fao.org/faostat/en/#data/QC (accessed on 20 February 2020).
- Al-Sharidah, A. Report of Black Scorch Disease on Date Palm Trees in the State of Kuwait. Am. Acad. Sci. Res. J. Eng. Technol. Sci. 2017, 28, 14–17. [Google Scholar]
- Abedalred, E.M.; Ismail, W.M.; Abdulmoohsin, R.G.; Al-Karhi, M.A. First molecular identification of Fusarium fujikuroi causing pollen rot of palm trees (Phoenix dactylifera L.) in Iraq and evaluation efficacy of some nanoparticles against it. In Proceedings of the IOP Conference Series: Earth and Environmental Science, Bristol, UK, 1 November 2019. [Google Scholar]
- Armstrong, G.M.; Armstrong, J.R. Forms specials and races of Fusarium oxysporum causing wilt diseases. In Fusarium: Diseases, Biology and Taxonomy; Nelson, P.E., Toussoun, T.A., Cook, R.J., Eds.; The Pennsylvania States University Press: University Park, PA, USA, 1981; pp. 391–393. [Google Scholar]
- Ahmed, Y.; Hussien, A.; El-badry, N.; Soliman, M.S. Validation of a Diagnostic Protocol for the Detection of Fusarium oxysporum f.sp. albedinis, the Causal Agent of Bayoud Disease of Date Palm. Egypt. J. Phytopathol. 2019, 47, 297–312. [Google Scholar] [CrossRef]
- OEPP/EPP. Fiches informatives sur les organismes de quarantaine n 70, Fusarium oxysporum f.sp. albedinis. Bulletin 1982, 12. Available online: https://gd.eppo.int/taxon/FUSAAL/datasheet (accessed on 6 December 2017).
- Bahriz, H.; Bouras, N. Etude de la Maladie du Bayoud, le Comportement Variétal du Palmier Dattier vis-à-vis du Fusarium oxysporum f.sp. albedinis dans la Vallée du M’Zab. Afr. Rev. Sci. Technol. Develop. 2020, 5, 41–60. [Google Scholar]
- EPPO (European and Mediterranean Plant Protection Organization). EPPO Global Database. Available online: https://gd.eppo.int (accessed on 6 December 2017).
- Bouhlali, E.D.T.; Derouich, M.; Ben-Amar, H.; Meziani, R.; Essarioui, A. Exploring the potential of using bioactive plant products in the management of Fusarium oxysporum f.sp. albedinis: The causal agent of Bayoud disease on date palm (Phoenix dactylifera L.). Beni-Seuf. Univ. J. Appl. Sci. 2020, 9, 1–9. [Google Scholar] [CrossRef]
- Djerbi, M. Diseases of the Palm Phoenix Dactylifera; FAO: Baghdad, Iraq, 1983; p. 45. [Google Scholar]
- Benzohra, I.E.; Megateli, M.; Elayachi, B.A.; Zekraoui, M.; Djillali, K.; Bouafia, A.; Benouis, S.; Benaziza, A.; Rekis, A. Integrated management of Bayoud disease on date palm (Phoenix dactylifera L.) caused by Fusarium oxysporum f.sp. albedinis in Algeria. JARA 2017, 14, 93–100. [Google Scholar]
- Djerbi, M. Les Maladies du Palmier Dattier. Projet Régional de Lutte Contre le Bayoud; FAO: Alger, Algeria, 1988; p. 127. [Google Scholar]
- EPPO. Diagnostic protocols for regulated pests PM 7/16 Fusarium oxysporum f.sp. albedinis. Bull. OEPP 2003, 33, 245–247. [Google Scholar]
- EFSA Panel on Plant Health (PLH); Jeger, M.; Bragard, C.; Caffier, D.; Candresse, T.; Chatzivassiliou, E.; Dehnen-Schmutz, K.; Gilioli, G.; Grégoire, J.C.; Jaques Miret, J.A.; et al. Pest categorisation of Fusarium oxysporum f.sp. albedinis. EFSA J. 2018, 16, e05183. [Google Scholar]
- Kaddouri, Y.; Abrigach, F.; Ouahhoud, S.; Benabbes, R.; El Kodadi, M.; Alsalme, A.; Al-Zaqri, N.; Warad, I.; Touzani, R. Mono-Alkylated Ligands Based on Pyrazole and Triazole Derivatives Tested Against Fusarium oxysporum f.sp. albedinis: Synthesis, Characterization, DFT, and Phytase Binding Site Identification Using Blind Docking/Virtual Screening for Potent Fophy Inhibitors. Front. Chem. 2020, 8, 559262. [Google Scholar] [CrossRef]
- De Lamo, F.J.; Takken, F.L. Biocontrol by Fusarium oxysporum using endophyte-mediated resistance. Front. Plant Sci. 2020, 11, 37. [Google Scholar] [CrossRef] [Green Version]
- Khan, N.; Martínez-Hidalgo, P.; Ice, T.A.; Maymon, M.; Humm, E.A.; Nejat, N.; Sanders, E.R.; Kaplan, D.; Hirsch, A.M. Antifungal activity of Bacillus species against Fusarium and analysis of the potential mechanisms used in biocontrol. Front. Microbiol. 2018, 9, 2363. [Google Scholar] [CrossRef] [PubMed] [Green Version]
- Sedra, M.H. La Maladie du Bayoud du Palmier Dattier en Afrique du Nord: Diagnostic et Caractérisation; Actes du Symposium International sur le Développement durable des Systèmes Oasiens: Erfoud, Marocco, 2005. [Google Scholar]
- Slama, H.B.; Cherif-Silini, H.; Chenari Bouket, A.; Qader, M.; Silini, A.; Yahiaoui, B.; Alenezi, F.N.; Luptakova, L.; Triki, M.A.; Vallat, A.; et al. Screening for Fusarium antagonistic bacteria from contrasting niches designated the endophyte Bacillus halotolerans as plant warden against Fusarium. Front. Microbiol. 2019, 9, 3236. [Google Scholar] [CrossRef] [Green Version]
- Slama, H.B.; Cherif-Silini, H.; Chenari Bouket, A.; Silini, A.; Alenezi, F.N.; Luptakova, L.; Vallat, A.; Belbahri, L. Biotechnology and bioinformatics of endophytes in biocontrol, Bioremediation, and plant growth promotion. In Endophytes: Mineral Nutrient Management; Maheshwari, D.K., Dheeman, S., Eds.; Springer: Cham, Switzerland, 2021; Volume 3, pp. 181–205. [Google Scholar] [CrossRef]
- Cherif-Silini, H.; Thissera, B.; Chenari Bouket, A.; Saadaoui, N.; Silini, A.; Eshelli, M.; Alenezi, F.N.; Vallat, A.; Luptakova, L.; Yahiaoui, B.; et al. Durum wheat stress tolerance induced by endophyte Pantoea agglomerans with genes contributing to plant functions and secondary metabolite arsenal. Int. J. Mol. Sci. 2019, 20, 3989. [Google Scholar] [CrossRef]
- Mefteh, F.B.; Daoud, A.; Chenari Bouket, A.; Thissera, B.; Kadri, Y.; Cherif-Silini, H.; Eshelli, M.; Alenezi, F.N.; Vallat, A.; Oszako, T.; et al. Date Palm Trees Root-Derived Endophytes as Fungal Cell Factories for Diverse Bioactive Metabolites. Int. J. Mol. Sci. 2018, 19, 1986. [Google Scholar] [CrossRef] [Green Version]
- Díaz-Valle, A.; López-Calleja, A.C.; Alvarez-Venegas, R. Enhancement of pathogen resistance in common bean plants by inoculation with Rhizobium etli. Front. Plant Sci. 2019, 10, 1317. [Google Scholar] [CrossRef]
- Alenezi, F.N.; Chenari Bouket, A.; Cherif-Silini, H.; Silini, A.; Jaspars, M.; Oszako, T.; Belbahri, L. Loss of Gramicidin Biosynthesis in Gram-Positive Biocontrol Bacterium Aneurinibacillus migulanus (Takagi et al., 1993) Shida et al. 1996 Emend Heyndrickx et al., 1997 Nagano Impairs Its Biological Control Ability of Phytophthora. Forests 2022, 13, 535. [Google Scholar] [CrossRef]
- Cherif-Silini, H.; Silini, A.; Chenari Bouket, A.; Alenezi, F.N.; Luptakova, L.; Bouremani, N.; Nowakowska, J.A.; Oszako, T.; Belbahri, L. Tailoring next generation plant growth promoting microorganisms as versatile tools beyond soil desalinization: A road map towards field application. Sustainability 2021, 13, 4422. [Google Scholar] [CrossRef]
- Pliego, C.; Ramos, C.; de Vicente, A.; Cazorla, F.M. Screening for candidate bacterial biocontrol agents against soilborne fungal plant pathogens. Plant Soil. 2011, 340, 505–520. [Google Scholar] [CrossRef] [Green Version]
- Knudsen, I.M.B.; Hockenhull, J.; Jensen, D.F.; Gerhardson, B.; Hökeberg, M.; Tahvonen, R.; Teperi, E.; Sundheim, L.; Henriksen, B. Selection of biological control agents for controlling soil and seed-borne diseases in the field. Eur. J. Plant Pathol. 1997, 103, 775–784. [Google Scholar] [CrossRef]
- Daayf, F.; Adam, L.; Fernando, W.G.D. Comparative screening of bacteria for biocontrol of potato late blight (strain US-8), using in-vitro, detached-leaves, and whole plant testing systems. Can. J. Plant Pathol. 2003, 25, 276–284. [Google Scholar] [CrossRef]
- Besset-Manzoni, Y.; Joly, P.; Brutel, A.; Gerin, F.; Soudiere, O.; Langin, T.; Prigent-Combaret, C. Does in vitro selection of biocontrol agents guarantee success in planta? A study case of wheat protection against Fusarium seedling blight by soil bacteria. PLoS ONE 2019, 14, e0225655. [Google Scholar] [CrossRef] [Green Version]
- Cherif-Silini, H.; Silini, A.; Yahiaoui, B.; Ouzari, I.; Boudabous, A. Phylogenetic and plant-growth-promoting characteristics of Bacillus isolated from the wheat rhizosphere. Ann. Microbiol. 2016, 66, 1087–1097. [Google Scholar] [CrossRef]
- Kerbab, S.; Silini, A.; Chenari Bouket, A.; Cherif-Silini, H.; Eshelli, M.; El Houda Rabhi, N.; Belbahri, L. Mitigation of NaCl stress in wheat by rhizosphere engineering using salt habitat adapted PGPR halotolerant bacteria. Appl. Sci. 2021, 11, 1034. [Google Scholar] [CrossRef]
- Rabhi, N.E.H.; Cherif-Silini, H.; Silini, A.; Alenezi, F.N.; Chenari Bouket, A.; Oszako, T.; Belbahri, L. Alleviation of Salt Stress via Habitat-Adapted Symbiosis. Forests 2022, 13, 586. [Google Scholar] [CrossRef]
- Shao, J.; Liu, Y.; Xie, J.; Stefanic, P.; Lv, Y.; Fan, B.; Mandic-Mulec, I.; Zhang, R.; Shen, Q.; Xu, Z. Annulment of Bacterial Antagonism Improves Plant Beneficial Activity of a Bacillus velezensis Consortium. Appl. Environ. Microbiol. 2022, 88, e0024022. [Google Scholar] [CrossRef]
- Borriss, R. Bacillus, A Plant-Beneficial Bacterium. In Principles of Plant-Microbe Interactions; Lugtenberg, B., Ed.; Springer: Cham, Switzerland, 2015. [Google Scholar] [CrossRef]
- Mac Faddin, J.F. Media for Isolation-Cultivation-Identification-Maintenance of Medical Bacteria; Williams and Wilkins: Baltimore, MD, USA, 1985; Volume 1. [Google Scholar]
- King, E.O.; Ward, M.; Raney, D.E.J. Two simple media for the demonstration of pyocyanin and fluorescein. Lab. Clin. Méd. 1954, 44, 301. [Google Scholar]
- Palumbo, J.D.; O’Keeffe, T.L. Method for high-throughput antifungal activity screening of bacterial strain libraries. J. Microbiol. Methods. 2021, 189, 106311. [Google Scholar] [CrossRef]
- Luchi, N.; Ghelardini, L.; Belbahri, L.; Quartier, M.; Santini, A. Rapid detection of Ceratocystis platani inoculum by quantitative Real-Time PCR assay. Appl. Environ. Microbiol. 2013, 79, 5394–5404. [Google Scholar] [CrossRef] [Green Version]
- Mefteh, F.B.; Chenari Bouket, A.; Daoud, A.; Luptakova, L.; Alenezi, F.N.; Gharsallah, N.; Belbahri, L. Metagenomic insights and genomic analysis of phosphogypsum and its associated plant endophytic microbiomes reveals valuable actors for waste bioremediation. Microorganisms 2019, 7, 382. [Google Scholar] [CrossRef] [Green Version]
- Li, T.; Tang, J.; Karuppiah, V.; Li, Y.; Xu, N.; Chen, J. Co-culture of Trichoderma atroviride SG3403 and Bacillus subtilis 22 improves the production of antifungal secondary metabolites. Biol. Control 2019, 140, 104122. [Google Scholar] [CrossRef]
- Dutta, S.; Woo, E.E.; Yu, S.M.; Nagendran, R.; Yun, B.S.; Lee, Y.H. Control of anthracnose and gray mold in pepper plants using culture extract of white-rot fungus and active compound schizostatin. Mycobiology 2019, 47, 87–96. [Google Scholar] [CrossRef] [Green Version]
- He, C.N.; Ye, W.Q.; Zhu, Y.Y.; Zhou, W.W. Antifungal activity of volatile organic compounds produced by Bacillus methylotrophicus and Bacillus thuringiensis against five common spoilage fungi on loquats. Molecules 2020, 25, 3360. [Google Scholar] [CrossRef] [PubMed]
- Yu, X.; Li, Y.; Zhang, C.; Liu, H.; Liu, J.; Zheng, W.; Kang, X.; Leng, X.; Zhao, K.; Gu, Y. Culturable heavy metal-resistant and plant growth promoting bacteria in V-Ti magnetite mine tailing soil from Panzhihua, China. PLoS ONE 2014, 9, e106618. [Google Scholar] [CrossRef] [PubMed]
- Patten, C.L.; Glick, B.R. Role of Pseudomonas putida indoleacetic acid in development of the host plant root system. Appl. Environ. Microbiol. 2002, 68, 3795–3801. [Google Scholar] [CrossRef] [Green Version]
- Olsen, R.S.; Sommers, L.E. Phosphorus. In Methods of Soil Analysis, Part 2: Chemical and Microbiological Properties, 2nd ed.; Pages, A.L., Miller, R.H., Keeney, D.R., Eds.; American Society of Agronomy: Madison, WI, USA, 1982; pp. 403–430. [Google Scholar]
- Schwyn, B.; Neilands, J.B. Universal chemical assay for the detection and determination of siderophores. Anal. Biochem. 1987, 160, 47–56. [Google Scholar] [CrossRef]
- Gokarn, K. Comments: Siderophore production by uropathogenic Escherichia coli. Indian J. Pathol. Microbiol. 2010, 53, 570. [Google Scholar] [CrossRef]
- Cappuccino, J.C.; Sherman, N. Microbiology: A Laboratory Manuel, 3rd ed.; Benjamin-Cummings Publishing Company: New York, NY, USA, 1992; pp. 125–179. [Google Scholar]
- Lorck, H. Production of hydrocyanic acid by bacteria. Physiol. Plant 1948, 1, 142–146. [Google Scholar] [CrossRef]
- Kumar, D.; Kumar, L.; Nagar, S.; Raina, C.; Parshad, R.; Gupta, V.K. Screening, isolation and production of lipase/esterase producing Bacillus sp. strain DVL2 and its potential evaluation in esterification and resolution reactions. Arch. Appl. Sci. Res. 2012, 4, 1763–1770. [Google Scholar]
- Loper, J.E.; Schroth, M.N. Influence of bacterial sources of indole- 3-acetic acid on root elongation of sugar beet. Phytopathology 1986, 76, 386–389. [Google Scholar] [CrossRef]
- Hashem, A.; Tabassum, B.; Abd_Allah, E.F. Bacillus subtilis: A plant-growth promoting rhizobacterium that also impacts biotic stress. Saudi J. Biol. Sci. 2019, 26, 1291–1297. [Google Scholar] [CrossRef] [PubMed]
- Huang, X.F.; Chaparro, J.M.; Reardon, K.F.; Zhang, R.; Shen, Q.; Vivanco, J.M. Rhizosphere interactions: Root exudates, microbes, and microbial communities. Botany 2014, 92, 267–275. [Google Scholar] [CrossRef]
- Djaya, L.; Istifadah, N.; Hartati, S.; Joni, I.M. In vitro study of plant growth promoting rhizobacteria (PGPR) and endophytic bacteria antagonistic to Ralstonia solanacearum formulated with graphite and silica nano particles as a biocontrol delivery system (BDS). Biocatal. Agric. Biotechnol. 2019, 19, 101153. [Google Scholar] [CrossRef]
- Vinayarani, G.; Prakash, H. Growth promoting rhizospheric and endophytic bacteria from Curcuma longa L. as biocontrol agents against rhizome rot and leaf blight diseases. Plant Pathol. J. 2018, 34, 218. [Google Scholar] [CrossRef]
- Khalil, M.M.R.; Fierro-Coronado, R.A.; Peñuelas-Rubio, O.; Villa-Lerma, A.G.; Plascencia-Jatomea, R.; Félix-Gastélum, R.; Maldonado-Mendoza, I.E. Rhizospheric bacteria as potential biocontrol agents against Fusarium wilt and crown and root rot diseases in tomato. Saudi J. Biol. Sci. 2021, 28, 7460–7471. [Google Scholar] [CrossRef]
- Cheffi, M.; Chenari Bouket, A.; Alenezi, F.N.; Luptakova, L.; Belka, M.; Vallat, A.; Rateb, M.E.; Tounsi, S.; Triki, M.A.; Belbahri, L. Olea europaea L. root endophyte Bacillus velezensis OEE1 counteracts oomycete and fungal harmful pathogens and harbours a large repertoire of secreted and volatile metabolites and beneficial functional genes. Microorganisms 2019, 7, 314. [Google Scholar] [CrossRef] [Green Version]
- Bernal, P.; Allsopp, L.P.; Filloux, A.; Llamas, M.A. The Pseudomonas putida T6SS is a plant warden against phytopathogens. ISME J. 2017, 11, 972–987. [Google Scholar] [CrossRef] [Green Version]
- Dihazi, A.; Jaiti, F.; Jaoua, S.; Driouich, A.; Baaziz, M.; Daayf, F.; Serghini, M.A. Use of two bacteria for biological control of bayoud disease caused by Fusarium oxysporum in date palm (Phoenix dactylifera L.) seedlings. Plant Physiol. Biochem. 2012, 55, 7–15. [Google Scholar] [CrossRef]
- Nishad, R.; Ahmed, T.A. Survey and identification of date palm pathogens and indigenous biocontrol agents. Plant Dis. 2020, 104, 2498–2508. [Google Scholar] [CrossRef]
- Pellegrini, M.; Pagnani, G.; Bernardi, M.; Mattedi, A.; Spera, D.M.; Gallo, M.D. Cell-free supernatants of plant growth-promoting bacteria: A review of their use as bio-stimulant and microbial biocontrol agents in sustainable agriculture. Sustainability 2020, 12, 9917. [Google Scholar] [CrossRef]
- Hong, S.; Kim, T.Y.; Won, S.-J.; Moon, J.-H.; Ajuna, H.B.; Kim, K.Y.; Ahn, Y.S. Control of Fungal Diseases and Fruit Yield Improvement of Strawberry Using Bacillus velezensis CE 100. Microorganisms 2022, 10, 365. [Google Scholar] [CrossRef] [PubMed]
- Jinal, H.N.; Sakthivel, K.; Amaresan, N. Characterization of antagonistic Bacillus paralicheniformis (strain EAL) by LC–MS, antimicrobial peptide genes, and ISR determinants. Antonie Leeuwenhoek. 2020, 113, 1167–1177. [Google Scholar] [CrossRef] [PubMed]
- Slama, H.B.; Triki, M.A.; Chenari Bouket, A.; Mefteh, F.B.; Alenezi, F.N.; Luptakova, L.; Cherif-Silini, H.; Vallat, A.; Oszako, T.; Gharsallah, N.; et al. Screening of the high-rhizosphere competent Limoniastrum monopetalum’culturable endophyte microbiota allows the recovery of multifaceted and versatile biocontrol agents. Microorganisms 2019, 7, 249. [Google Scholar] [CrossRef] [Green Version]
- Chen, K.; Tian, Z.; He, H.; Long, C.A.; Jiang, F. Bacillus species as potential biocontrol agents against citrus diseases. Biol. Control 2020, 151, 104419. [Google Scholar] [CrossRef]
- Secaira-Morocho, H.; Castillo, J.A.; Driks, A. Diversity and evolutionary dynamics of spore-coat proteins in spore-forming species of Bacillales. Microb. Genom. 2020, 6, mgen000451. [Google Scholar] [CrossRef]
- Ahmed, H.F.A.; Seleiman, M.F.; Al-Saif, A.M.; Alshiekheid, M.A.; Battaglia, M.L.; Taha, R.S. Biological Control of Celery Powdery Mildew Disease Caused by Erysiphe heraclei DC In Vitro and In Vivo Conditions. Plants 2021, 10, 2342. [Google Scholar] [CrossRef]
- Belbahri, L.; Chenari Bouket, A.; Rekik, I.; Alenezi, F.N.; Vallat, A.; Luptakova, L.; Petrovova, E.; Oszako, T.; Cherrad, S.; Vacher, S.; et al. Comparative genomics of Bacillus amyloliquefaciens strains reveals a core genome with traits for habitat adaptation and a secondary metabolites rich accessory genome. Front. Microbiol. 2017, 8, 1438. [Google Scholar] [CrossRef] [Green Version]
- Attia, M.S.; El-Sayyad, G.S.; Abd Elkodous, M.; El-Batal, A.I. The effective antagonistic potential of plant growth-promoting rhizobacteria against Alternaria solani-causing early blight disease in tomato plant. Sci. Hort. 2020, 266, 109289. [Google Scholar] [CrossRef]
- Hong, P.; Hao, W.; Luo, J.; Chen, S.; Hu, M.; Zhong, G. Combination of hot water, Bacillus amyloliquefaciens HF-01 and sodium bicarbonate treatments to control postharvest decay of mandarin fruit. Postharvest Biol. Technol. 2014, 88, 96–102. [Google Scholar] [CrossRef]
- Malgioglio, G.; Rizzo, G.F.; Nigro, S.; Lefebvre du Prey, V.; Herforth-Rahmé, J.; Catara, V.; Branca, F. Plant-Microbe Interaction in Sustainable Agriculture: The Factors That May Influence the Efficacy of PGPM Application. Sustainability 2022, 14, 2253. [Google Scholar] [CrossRef]
- Villarreal-Delgado, M.F.; Villa-Rodríguez, E.D.; Cira-Chávez, L.A.; Estrada-Alvarado, M.I.; Parra-Cota, F.I.; Santos-Villalobos, S.D.L. The genus Bacillus as a biological control agent and its implications in the agricultural biosecurity. Rev. Mex. Fitopatol. 2018, 36, 95–130. [Google Scholar]
- Balla, A.; Silini, A.; Cherif-Silini, H.; Chenari Bouket, A.; Moser, W.K.; Nowakowska, J.A.; Oszako, T.; Benia, F.; Belbahri, L. The Threat of Pests and Pathogens and the Potential for Biological Control in Forest Ecosystems. Forests 2021, 12, 1579. [Google Scholar] [CrossRef]
- Palmieri, D.; Vitullo, D.; De Curtis, F.; Lima, G. A microbial consortium in the rhizosphere as a new biocontrol approach against Fusarium decline of chickpea. Plant Soil. 2017, 412, 425–439. [Google Scholar] [CrossRef]
- Mukherjee, A.; Chouhan, G.K.; Gaurav, A.K.; Jaiswal, D.K.; Verma, J.P. Development of indigenous microbial consortium for biocontrol management. In New and Future Developments in Microbial Biotechnology and Bioengineering; Verma, J.P., Gupta, V.K., Macdonald, C.A., Podile, A.R., Eds.; Elsevier: Amsterdam, The Netherland, 2021; pp. 91–104. [Google Scholar]
- Niu, B.; Wang, W.; Yuan, Z.; Sederoff, R.R.; Sederoff, H.; Chiang, V.L.; Borriss, R. Microbial interactions within multiple-strain biological control agents impact soil-borne plant disease. Front. Microbiol. 2020, 11, 585404. [Google Scholar] [CrossRef] [PubMed]
- Saidi, S.; Cherif-Silini, H.; Chenari Bouket, A.; Silini, A.; Eshelli, M.; Luptakova, L.; Alenezi, F.N.; Belbahri, L. Improvement of Medicago sativa crops productivity by the co-inoculation of Sinorhizobium meliloti–actinobacteria under salt stress. Curr. Microbiol. 2021, 78, 1344–1357. [Google Scholar] [CrossRef] [PubMed]
- Thomloudi, E.E.; Tsalgatidou, P.C.; Douka, D.; Spantidos, T.N.; Dimou, M.; Venieraki, A.; Katinakis, P. Multistrain versus single-strain plant growth promoting microbial inoculants-The compatibility issue. Hell. Plant Prot. J. 2019, 12, 61–77. [Google Scholar] [CrossRef]
- Jiao, X.; Takishita, Y.; Zhou, G.; Smith, D.L. Plant associated rhizobacteria for biocontrol and plant growth enhancement. Front. Plant Sci. 2021, 12, 634796. [Google Scholar] [CrossRef] [PubMed]
- Alenezi, F.N.; Slama, H.B.; Chenari Bouket, A.; Cherif-Silini, H.; Silini, A.; Luptakova, L.; Nowakowska, J.A.; Oszako, T.; Belbahri, L. Bacillus velezensis: A Treasure House of Bioactive Compounds of Medicinal, Biocontrol and Environmental Importance. Forests 2021, 12, 1714. [Google Scholar] [CrossRef]
- Wang, H.; Liu, R.; You, M.P.; Barbetti, M.J.; Chen, Y. Pathogen Biocontrol Using Plant Growth-Promoting Bacteria (PGPR): Role of Bacterial Diversity. Microorganisms 2021, 9, 1988. [Google Scholar] [CrossRef]
- Wang, X.; Liang, L.; Shao, H.; Ye, X.; Yang, X.; Chen, X.; Shi, Y.; Zhang, L.; Xu, L.; Wang, J. Isolation of the Novel Strain Bacillus amyloliquefaciens F9 and Identification of Lipopeptide Extract Components Responsible for Activity against Xanthomonas citri subsp. citri. Plants 2022, 11, 457. [Google Scholar] [CrossRef] [PubMed]
- Ruano-Rosa, D.; Cazorla, F.M.; Bonilla, N.; Martín-Pérez, R.; De Vicente, A.; López-Herrera, C.J. Biological control of avocado white root rot with combined applications of Trichoderma spp. and rhizobacteria. Eur. J. Plant Pathol. 2014, 138, 751–762. [Google Scholar] [CrossRef]
- Alamri, S.; Hashem, M.; Mostafa, Y.S. In vitro and in vivo biocontrol of soil-borne phytopathogenic fungi by certain bioagents and their possible mode of action. Biocontrol Sci. 2012, 17, 155–167. [Google Scholar] [CrossRef] [PubMed] [Green Version]
- Li, X.; Wang, X.; Shi, X.; Wang, B.; Li, M.; Wang, Q.; Zhang, S. Antifungal effect of volatile organic compounds from Bacillus velezensis CT32 against Verticillium dahliae and Fusarium oxysporum. Processes 2020, 8, 1674. [Google Scholar] [CrossRef]
- Che, J.; Liu, B.; Liu, G.; Chen, Q.; Lan, J. Volatile organic compounds produced by Lysinibacillus sp. FJAT-4748 possess antifungal activity against Colletotrichum acutatum. Biocontrol Sci. Technol. 2017, 27, 1349–1362. [Google Scholar] [CrossRef]
- Chaves-López, C.; Serio, A.; Gianotti, A.; Sacchetti, G.; Ndagijimana, M.; Ciccarone, C.; Stellarini, A.; Corsetti, A.; Paparella, A. Diversity of food-borne Bacillus volatile compounds and influence on fungal growth. J. Appl. Microbiol. 2015, 119, 487–499. [Google Scholar] [CrossRef] [PubMed]
- Morita, T.; Tanaka, I.; Ryuda, N.; Ikari, M.; Ueno, D.; Someya, T. Antifungal spectrum characterization and identification of strong volatile organic compounds produced by Bacillus pumilus TM-R. Heliyon 2019, 5, e01817. [Google Scholar] [CrossRef]
- Ngo, T.T.; Dart, P.; Callaghan, M.; Klieve, A.; McNeill, D. Volatile Organic Compound Profiles Associated with Microbial Development in Feedlot Pellets Inoculated with Bacillus amyloliquefaciens H57 Probiotic. Animals 2021, 11, 3227. [Google Scholar] [CrossRef]
- Morales-Cedeno, L.R.; del Carmen Orozco-Mosqueda, M.; Loeza-Lara, P.D.; Parra-Cota, F.I.; de Los Santos-Villalobos, S.; Santoyo, G. Plant growth-promoting bacterial endophytes as biocontrol agents of pre-and post-harvest diseases: Fundamentals, methods of application and future perspectives. Microbiol. Res. 2021, 242, 126612. [Google Scholar] [CrossRef]
- Santhanam, R.; Menezes, R.C.; Grabe, V.; Li, D.; Baldwin, I.T.; Groten, K. A suite of complementary biocontrol traits allows a native consortium of root-associated bacteria to protect their host plant from a fungal sudden-wilt disease. Mol. Ecol. 2019, 28, 1154–1169. [Google Scholar] [CrossRef]
- Posada, L.F.; Álvarez, J.C.; Romero-Tabarez, M.; de-Bashan, L.; Villegas-Escobar, V. Enhanced molecular visualization of root colonization and growth promotion by Bacillus subtilis EA-CB0575 in different growth systems. Microbiol. Res. 2018, 217, 69–80. [Google Scholar] [CrossRef] [PubMed]
- Lamari, L.; Bouras, N.; Boudjella, H.; Ould EL Hadj-Khelil, A.; Ould El Hadj, M.D.; Sabaou, N. Influence de quelques souches bactériennes d’origine saharienne sur l’expression de la fusariose du lin et du palmier dattier. Algerian J. Arid Environ. 2014, 4, 65–77. [Google Scholar]
- Miljaković, D.; Marinković, J.; Balešević-Tubić, S. The significance of Bacillus spp. in disease suppression and growth promotion of field and vegetable crops. Microorganisms 2020, 8, 1037. [Google Scholar] [CrossRef]
- Verma, P.P.; Shelake, R.M.; Das, S.; Sharma, P.; Kim, J.Y. Plant growth-promoting rhizobacteria (PGPR) and fungi (PGPF): Potential biological control agents of diseases and pests. In Microbial Interventions in Agriculture and Environment; Singh, D., Gupta, V., Prabha, R., Eds.; Springer: Singapore, 2019; pp. 281–311. [Google Scholar] [CrossRef]
- Wang, X.Q.; Zhao, D.L.; Shen, L.L.; Jing, C.L.; Zhang, C.S. Application and mechanisms of Bacillus subtilis in biological control of plant disease. In Role of Rhizospheric Microbes in Soil; Meena, V., Ed.; Springer: Singapore, 2018; pp. 225–250. [Google Scholar] [CrossRef]
- Yu, Y.; Gui, Y.; Li, Z.; Jiang, C.; Guo, J.; Niu, D. Induced systemic resistance for improving plant immunity by beneficial microbes. Plants 2022, 11, 386. [Google Scholar] [CrossRef]
- Jiang, C.H.; Yao, X.F.; Mi, D.D.; Li, Z.J.; Yang, B.Y.; Zheng, Y.; Qi, Y.-J.; Guo, J.H. Comparative transcriptome analysis reveals the biocontrol mechanism of Bacillus velezensis F21 against Fusarium wilt on watermelon. Front. Microbiol. 2019, 10, 652. [Google Scholar] [CrossRef] [PubMed]
- Kumar, B.P.; Trimurtulu, N.; Gopal, A.V. Potential Screening of Indigenous Drought Stress Tolerant Bacteria for Plant Growth Promotion (PGP) Traits: An In-vitro Study. Int. Res. J. Pure Appl. Chem. 2020, 22, 8–21. [Google Scholar] [CrossRef]
- Cui, W.; He, P.; Munir, S.; He, P.; Li, X.; Li, Y.; Li, Y.; Wu, J.; Wu, Y.; Yang, L.; et al. Efficacy of plant growth promoting bacteria Bacillus amyloliquefaciens B9601-Y2 for biocontrol of southern corn leaf blight. Biol. Control 2019, 139, 104080. [Google Scholar] [CrossRef]
- Kaur, R.; Kaur, S.; Kaur, N. Phosphate Solubilizing Bacteria: A Neglected Bioresource for Ameliorating Biotic Stress in Plants. In Plant-Microbe Dynamics: Recent Advances for Sustainable Agriculture; Pirzadah, T.B., Malik, B., Hakeem, K.R., Eds.; CRC Press: Boca Raton, FL, USA, 2021; pp. 39–50. [Google Scholar]
- Rabhi, N.E.H.; Silini, A.; Cherif-Silini, H.; Yahiaoui, B.; Lekired, A.; Robineau, M.; Esmaeel, Q.; Jacquard, C.; Vaillant-Gaveau, N.; Clément, C.; et al. Pseudomonas knackmussii MLR6, a rhizospheric strain isolated from halophyte, enhances salt tolerance in Arabidopsis thaliana. J. Appl. Microbiol. 2018, 125, 1836–1851. [Google Scholar] [CrossRef]
- Goswami, M.; Deka, S. Isolation of a novel rhizobacteria having multiple plant growth promoting traits and antifungal activity against certain phytopathogens. Microbiol. Res. 2020, 240, 126516. [Google Scholar] [CrossRef]
- Singh, M.; Singh, D.; Gupta, A.; Pandey, K.D.; Singh, P.K.; Kumar, A. Plant growth promoting rhizobacteria: Application in biofertilizers and biocontrol of phytopathogens. In PGPR Amelioration in Sustainable Agriculture; Singh, A.K., Kumar, A., Singh, P.K., Eds.; Woodhead Publishing: Sawston, UK, 2019; pp. 41–66. [Google Scholar]
- Jadhav, H.P.; Shaikh, S.S.; Sayyed, R.Z. Role of hydrolytic enzymes of rhizoflora in biocontrol of fungal phytopathogens: An overview. In Rhizotrophs: Plant Growth Promotion to Bioremediation; Mehnaz, S., Ed.; Springer: Singapore, 2017; pp. 183–203. [Google Scholar] [CrossRef]
- Muniroh, M.S.; Nusaibah, S.A.; Vadamalai, G.; Siddique, Y. Proficiency of biocontrol agents as plant growth promoters and hydrolytic enzyme producers in Ganoderma boninense infected oil palm seedlings. Curr. Plant Biol. 2019, 20, 100116. [Google Scholar] [CrossRef]
- Radhakrishnan, R.; Hashem, A.; Abd_Allah, E.F. Bacillus: A biological tool for crop improvement through bio-molecular changes in adverse environments. Front. Physiol. 2017, 8, 667. [Google Scholar] [CrossRef] [PubMed] [Green Version]
- Silini-Cherif, H.; Silini, A.; Ghoul, M.; Yadav, S. Isolation and characterization of plant growth promoting traits of a rhizobacteria: Pantoea agglomerans lma2. Pakistan J. Biol. Sci. PJBS 2012, 15, 267–276. [Google Scholar] [CrossRef] [PubMed] [Green Version]
- Silini, A.; Cherif-Silini, H.; Yahiaoui, B. Growing varieties durum wheat (Triticum durum) in response to the effect of osmolytes and inoculation by Azotobacter chroococcum under salt stress. Afr. J. Microbiol. Res. 2016, 10, 387–399. [Google Scholar]
- Praveen Kumar, G.; Mir Hassan Ahmed, S.K.; Desai, S.; Leo Daniel Amalraj, E.; Rasul, A. In vitro screening for abiotic stress tolerance in potent biocontrol and plant growth promoting strains of Pseudomonas and Bacillus spp. Int. J. Bacteriol. 2014, 2014, 195946. [Google Scholar] [CrossRef] [PubMed] [Green Version]
- Chari, K.D.; Reddy, R.S.; Triveni, S.; Trimurtulu, N.; Rani, C.V.D.; Sreedhar, M. Isolation and characterization of abiotic stress tolerant plant growth promoting Bacillus spp. from different rhizospheric soils of Telangana. Biosci. Biotechnol. Res. Asia 2018, 15, 485–494. [Google Scholar] [CrossRef]
- Ramakrishna, W.; Rathore, P.; Kumari, R.; Yadav, R. Brown gold of marginal soil: Plant growth promoting bacteria to overcome plant abiotic stress for agriculture, biofuels and carbon sequestration. Sci. Total Environ. 2020, 711, 135062. [Google Scholar] [CrossRef] [PubMed]
- Nazli, F.; Mustafa, A.; Ahmad, M.; Hussain, A.; Jamil, M.; Wang, X.; Shakeel, Q.; Imtiaz, M.; El-Esawi, M.A. A review on practical application and potentials of phytohormone-producing plant growth-promoting rhizobacteria for inducing heavy metal tolerance in crops. Sustainability 2020, 12, 9056. [Google Scholar] [CrossRef]

Publisher’s Note: MDPI stays neutral with regard to jurisdictional claims in published maps and institutional affiliations. |
© 2022 by the authors. Licensee MDPI, Basel, Switzerland. This article is an open access article distributed under the terms and conditions of the Creative Commons Attribution (CC BY) license (https://creativecommons.org/licenses/by/4.0/).
Share and Cite
Boulahouat, S.; Cherif-Silini, H.; Silini, A.; Chenari Bouket, A.; Luptakova, L.; Saadaoui, N.; Alenezi, F.N.; Belbahri, L. Critical Evaluation of Biocontrol Ability of Bayoud Infected Date Palm Phyllospheric Bacillus spp. Suggests That In Vitro Selection Does Not Guarantee Success in Planta. Agronomy 2022, 12, 2403. https://doi.org/10.3390/agronomy12102403
Boulahouat S, Cherif-Silini H, Silini A, Chenari Bouket A, Luptakova L, Saadaoui N, Alenezi FN, Belbahri L. Critical Evaluation of Biocontrol Ability of Bayoud Infected Date Palm Phyllospheric Bacillus spp. Suggests That In Vitro Selection Does Not Guarantee Success in Planta. Agronomy. 2022; 12(10):2403. https://doi.org/10.3390/agronomy12102403
Chicago/Turabian StyleBoulahouat, Sarah, Hafsa Cherif-Silini, Allaoua Silini, Ali Chenari Bouket, Lenka Luptakova, Nora Saadaoui, Faizah N. Alenezi, and Lassaad Belbahri. 2022. "Critical Evaluation of Biocontrol Ability of Bayoud Infected Date Palm Phyllospheric Bacillus spp. Suggests That In Vitro Selection Does Not Guarantee Success in Planta" Agronomy 12, no. 10: 2403. https://doi.org/10.3390/agronomy12102403





